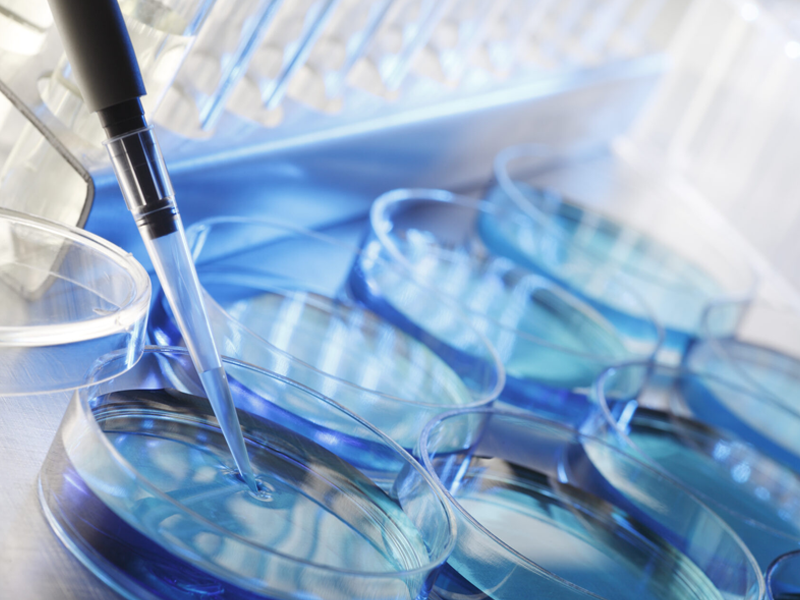
3.png

再生医療とは、ケガや病気などにより機能障害に陥った組織、臓器、細胞などを元通りに戻すために、ヒトが持っている「再生する力」を用いた治療法です。
具体的には、身体の自然治癒力を高めることにより、失われた組織や機能などの修復・再生を行います。この再生医療は、身体の持つ驚くべき能力を活かした最新の治療方法です。
ヒトは、精子と卵子が結びついて受精卵となるところから始まります。この受精卵は細胞分裂を繰り返すことで筋肉、神経、皮膚、骨など、身体の様々な部分を形成し、約280日かけてヒトの形を作り上げます。
このように、ヒトは最初に1つの細胞から始まります。ヒトの身体は約60兆個の細胞で構成されており、生命活動を維持するために常に新しい細胞と古い細胞が入れ替わります。人間に限らず、あらゆる生物は1つの細胞が集まってできているのです。

人間の身体には、受精卵のように様々な形に変化できる特別な細胞が存在します。
これらの特殊な細胞は「幹細胞」と呼ばれます。通常、幹細胞は休眠状態にありますが、身体の細胞が損傷したり、細胞数が不足したと感知すると、自ら細胞分裂を行い、傷ついた細胞や不足している細胞の代わりとなり、身体の機能を修復する役割があります。
幹細胞を活用した再生医療は、これらの特殊な細胞の自己修復能力を活性化し、摩耗した軟骨や本来の機能を喪失した臓器に対して働きかけ、本来の身体機能を回復させる治療法です。
つまり、通常の休息や食事では回復が難しい部分において、自身の細胞を活用して修復を促進するアプローチと言えます。

1.体への負担が少なく安全な採取方法
腹部の脂肪から少量の組織を採取するため、患者様の身体への負担は非常に軽減されています。局所麻酔を使用し、短時間で手軽に処置を行えるため、安心して治療を受けていただけます
2.ご自身の細胞だから拒絶反応の心配がほとんどなし
自家由来の幹細胞を使用するため、アレルギー反応や免疫拒絶が起こりにくいのも大きなメリットです。安心してご利用いただける治療法として、多くの患者様から信頼を得ています。
3.多岐にわたる症状の改善に期待できる
脂肪由来幹細胞は、関節や軟骨の修復、内科疾患の改善、神経系の損傷回復、美容分野での若返り効果など、幅広い用途での活用が研究されています。症状や目的に応じて最適な治療プランをご提案いたします。
| 整形外科 | 1.ひざの痛み(変形性ひざ関節症) |
|---|---|
| 脳神経・内科 | 1.脳卒中 |
| 美容・免疫 | 1.美容(肌の再生医療) |
NK細胞療法は、体内に強力な免疫の戦士を増強し、がん細胞などの異常細胞を効果的に監視・排除する治療法です。
患者さま自身の血液からNK細胞を取り出し、培養技術で数を増やし活性化させた後、点滴で体内に戻します。
このプロセスにより、通常よりも多くの活性化NK細胞が全身を巡り、免疫システム全体の力が大幅にアップします。強化された免疫は、がん細胞だけでなくウイルスや細菌から身体を守る働きも高めます。
自分の細胞を使うため、副作用が非常に少なく、安全に免疫力を底上げできるのが大きな特徴です。
活性化されたNK細胞はがん細胞を直接攻撃し、その増殖を抑えます。
培養した自身の細胞を使用するため、体への負担が少なく、治療中も普段通りの生活を維持しやすいのがメリットです。
NK細胞療法は、体内に強力な免疫の戦士を増強し、がん細胞などの異常細胞を効果的に監視・排除する治療法です。
・がんの発症を未然に防ぎたい方
・がんの再発リスクを減らしたい方
・加齢による免疫力の低下を感じている方
NK細胞の数を維持することで、風邪やインフルエンザなどの感染症にも強くなり、健康な毎日をサポートします。年齢を問わず、健康維持のための効果的な方法といえるでしょう。
ヒト由来の幹細胞を培養・増殖する過程で得られる、高純度の上澄み液を幹細胞培養上清といい、この培養上清には幹細胞治療と類似する効果が期待されています。 体内に存在する間葉系幹細胞には、歯髄・臍帯(さいたい)・骨髄・脂肪などがありますが、当院では「ヒト臍帯由来の幹細胞培養上清」、「ヒト歯髄由来の幹細胞培養上清」、「ヒト脂肪由来の幹細胞培養上清」の3種類の治療法をご用意しています。
幹細胞培養上清液には数百種類ものサイトカイン群が含まれています。サイトカインとは細胞から分泌される低分子のタンパク質であり、生理活性物質の総称です。
これら生理活性物質が肌のターンオーバーを促進したり、抗炎症作用や創傷治癒作用が働き、体内の損傷している部位の細胞を活性化する性質をもつことから、様々な症状を改善することが期待されます。
| 臍帯(さい帯)由来 | さい帯とは赤ちゃんと母体をつなぐへその緒のことで、へその緒を流れる血液のことを『さい帯血』と呼びます。さい帯血には血液を造る細胞(造血幹細胞)が多く含まれていて、機能障害や白血病などの血液疾患治療として使用されることが多いです。 |
|---|---|
| 脂肪由来 | 骨髄由来と同等の能力をもち、より多くの幹細胞を確保できる脂肪由来の間葉系幹細胞の多くは脂肪吸引によって抽出された脂肪を使用します。 |
| 歯髄(しずい)由来 | 子供の乳歯の細胞を採取し、培養した過程で得られる上澄み液を使用します。歯髄(しずい)は象牙質やエナメル質に囲まれているため、がん細胞の侵入など外部からの影響を受けにくく非常に質がよい幹細胞を含んでいるといわれています。 |
| 骨髄由来 | ヒトの骨髄から採取された幹細胞で、脊髄損傷に伴う神経症や機能障害の改善の他、血液疾患治療で使用されることがほとんどです。痛みが伴い、採取が困難なため、現在では厚労省から使用法についてガイドラインが出されています。 |
ヒトのへその緒(臍帯)から採取される幹細胞は、赤ちゃんの成長に関わる非常に若くて活性の高い細胞です。これらの幹細胞を培養した際に得られる「培養上清液」にはサイトカインが豊富に含まれており、特に血液疾患(白血病・再生不良性貧血など)や脳性麻痺、発達障害などの治療において注目されています。
子どもの乳歯や親知らずの歯髄から採取される幹細胞は、高い再生力を持っているとされ、「歯髄由来幹細胞」は特に注目されています。この幹細胞を培養して得られる上清液は、組織修復や神経系へのアプローチなど、多目的な再生医療に利用されています。
腹部などから採取される脂肪組織から抽出した幹細胞を培養し得られる上清液には、成長因子や免疫・抗炎症関連のサイトカインが豊富に含まれています。アンチエイジング、疲労回復、育毛、睡眠改善など、美容・体調サポートとして幅広い目的に用いられています。
各上清には、PDGF、TGF-β、HGF、VEGF、EGF など多数のサイトカインが含まれ、細胞修復・抗炎症・育毛・皮膚再生・神経保護など多様な効果が期待されています。
PRP(Platelet Rich Plasma:多血小板血漿)とは、「血小板を多量に含む血漿」のことを指します。
PRP(多血小板血漿)は、自身の血液を遠心分離にかけ、血小板を濃縮した液体を精製します。血液に含まれる血小板は、傷ついた組織や細胞に集まり、成長因子を放出します。
これにより組織の修復が促進され、新しい細胞の成長を促し、自己治癒力を高めることができます。この働きを利用して、傷ついた組織や細胞を修復し、痛みを軽減する治療法です。
PRP(多血小板血漿)療法では、高濃度に濃縮されたPRPを損傷している組織や細胞に対して、自然治癒を促していきます。修復が促された部位では、組織の修復や抗炎症作用が働くことで痛みの軽減などが期待できます。

・四十肩・五十肩、肩関節周囲炎
・腱鞘炎、肩腱板損傷、半月板損傷
・膝靭帯損傷、変形性ひざ関節症、変形性股関節症
・インピンジメント症候群、膝蓋腱炎(ジャンパー膝)
・ゴルフ肘・テニス肘、手首や足首の靭帯損傷
・アキレス腱炎、足底腱膜炎、オスグッド病
・肉離れ(筋断裂)、TFCC損傷
・美容領域:肌再生(アンチエイジング)、毛髪再生(AGA治療)
がんに対する従来の三大治療法(手術療法、化学療法、放射線療法)は、がん細胞の除去や殺傷を目的としていますが、同時に正常な臓器や細胞にも影響を及ぼし、副作用により治療継続が難しくなる場合があります。
近年では、患者さんの生活の質(QOL)を重視した『新しいがん治療』への関心が高まっており、副作用を抑えつつQOLを維持する治療法が求められています。
がん免疫治療は、従来の治療法が直接がん細胞を攻撃するのに対し、人間が本来持つ免疫力を高めることでがん細胞の増殖を抑え、副作用の少ない治療法として注目されています。
当社では、最先端の医療技術を活用し、高品質ながん免疫治療に関するサービスを提供するとともに、細胞再生医療研究所を併設し、研究開発にも取り組んでいます。患者様のQOLを考慮した、病状に合わせた治療法のご提案を目指しています。
